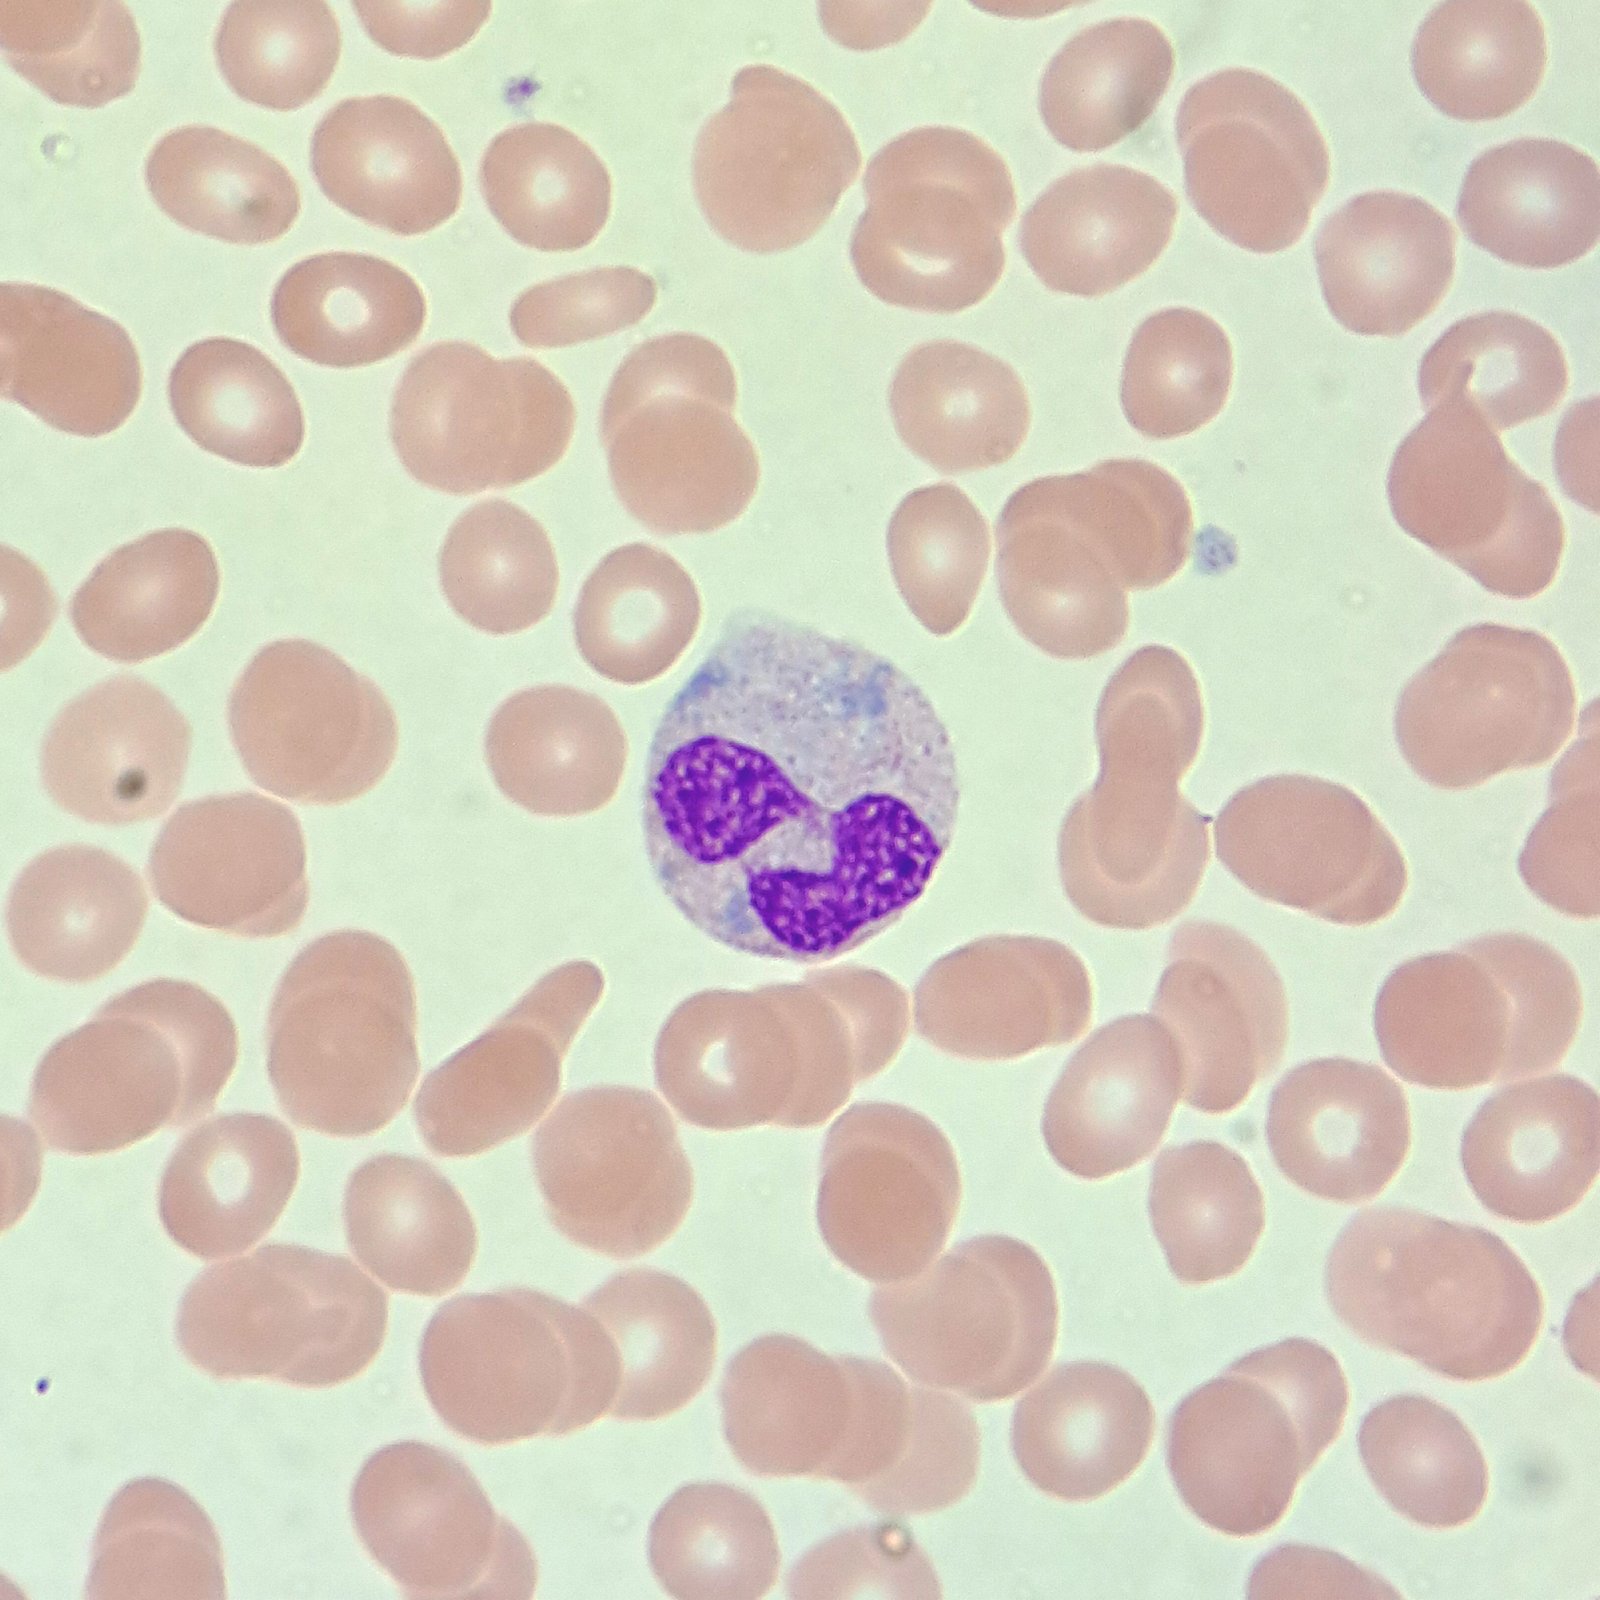
Dohle Body Inclusions in Neutrophil

Critical green inclusions in neutrophils are also informally known as “Green Crystals of Death” due to being associated with poor prognosis. They are a finding typically seen in critically ill patients.
Appearance
Critical green inclusions are bright green/blue refractile inclusions in the cytoplasm.

Lookalikes
Critical green inclusions can be misidentified as dohle bodies, especially as these inclusions are not seen very often. They are bright green in color instead of pale blue, however.
Gallery